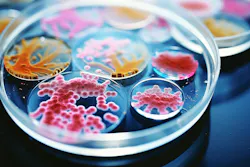
67bddd0328e452dadc2e36c4 Dreamstime Xxl 317078522 67bddd0328e452dadc2e36c4 Dreamstime Xxl 317078522

Researchers from the University of California, Irvine have developed a drug that could treat bacteria before it becomes drug resistant.
The antibiotics are an extension of vancomycin that “targets, bonds to and renders inactive two different parts of a molecule on the surfaces of pathogenic bacteria,” according to a release. The drug could “eliminate the need for researchers to continuously design new drugs to treat newly evolved strains of antibiotic-resistant bacteria.”
The study is published in the Journal of the American Chemical Society.
About the Author
Sign up for our eNewsletters
Get the latest news and updates